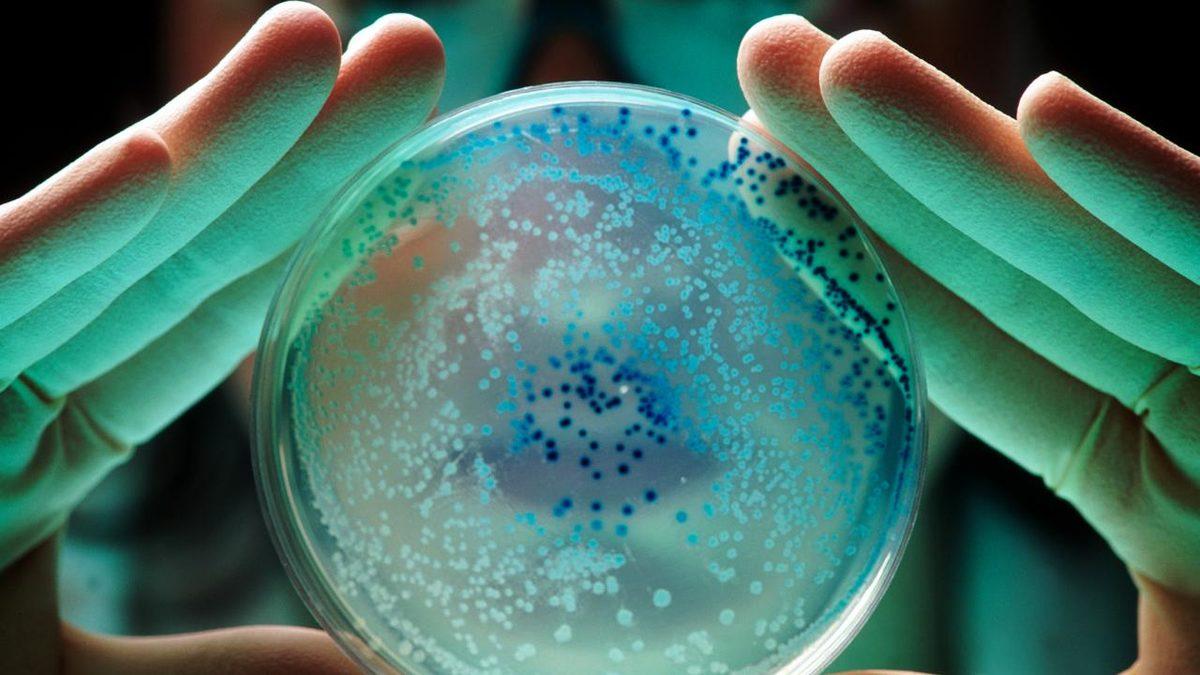
Derimizdeki Bakteri ve Mikropların Vücudumuzdaki Yararlarını Öğrenince Onlardan Nefret Edemeyeceksiniz!

Vücudumuzun her santimetrekaresinde 10.000 ila bir milyon bakteri yaşıyor. Bu oldukça tiksindirici gelebilir, değil mi?
Aslında durum tam tersi! Derimizdeki mikroplar sağlığımızı korumada kritik bir rol oynuyor ve bize birçok şaşırtıcı fayda sağlıyor.
Deri mikrobiyotamızın faydaları nelerdir?
Bağırsak mikrobiyotasını duymuşsunuzdur, bağırsaklarımızda yaşayan mikropların çeşitli hastalıklarla ilişkili olduğunu biliyoruz. Aynı şekilde cildimizdeki mikroplar da ilk savunma hattımızı oluşturur ve patojenlerin derimize yerleşmesini engeller.
Cilt mikrobiyotası, bağışıklık sistemimizin gelişiminde de önemli bir rol oynar. Özellikle çocukluk döneminde bağışıklık sistemimizin hedefleri öğrenmesine yardımcı olur. Bazı bakterilerin çeşitliliği, alerji riskinin azalması ile ilişkilidir.
Her bölge farklı mikroplara ev sahipliği yapar.
Alnınız, burnunuz veya sırtınızda, sebumla beslenen Cutibacterium bulabilirsiniz. Koltuk altlarınızda ise Staphylococcus ve Corynebacterium gibi bakteriler bulunur. Ayak parmaklarınızın arasında Propionibacterium ve çeşitli mantar türleri yaşar.
Bu mikroplar, cildimizle bir tür simbiyotik ilişki kurmuştur. Bize besin sağlarlar, biz ise zararlı patojenlere karşı savunma sağlarız. Staphylococcus epidermidis gibi bakteriler, zararlı bakterilerin büyümesini engelleyici kimyasallar üretir.
Cilt mikrobiyotamızın dengesi bozulduğunda egzama, akne ve sedef hastalığı gibi durumlar ortaya çıkabilir.

Kötü bakteriler, yaşlanma sürecini hızlandırabilir ve yaraların iyileşmesini geciktirebilir. Örneğin, Staphylococcus aureus yaraların iyileşmesini engelleyebilir. Ancak cilt mikroplarımızın UV ışınlarının zararlı etkilerine karşı bile koruma sağlayabileceğine dair kanıtlar var.
UV ışınları cildimize zarar verdiğinde, cilt mikroplarımız bağışıklık sistemimizi uyararak enfeksiyonla savaşmamıza yardımcı olabilir.
Sağlığımızı iyileştirmek için kötü bakterileri iyi bakterilerle değiştirebilir miyiz? Belki olabilir ancak bunu yapmak, mevcut mikrobiyal topluluğu yok etmek anlamına gelebilir.

Bazı şirketler, cildi "prebiyotikler" ve "probiyotikler" ile tedavi ederek sağlıklı mikropların büyümesini teşvik etmeye çalışıyor. Ayrıca bakteriyel proteinler veya lipidleri doğrudan cildimize uygulamak da bir seçenek olabilir.
Hull Üniversitesi'nde yara iyileşmesi üzerine ders veren akademisyen Holly Wilkinson ve meslektaşları, özel virüslerin ve moleküllerinin zararlı bakterileri hedef alarak cilt mikrobiyotasını zarar vermeden yok edebileceğini araştırıyor. Bu, enfeksiyonların tedavisinde büyük bir değişiklik yaratabilir.





